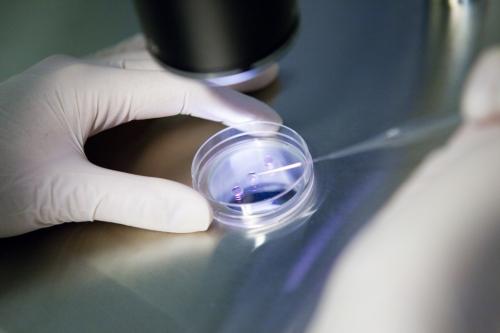
Image

Genetic Considerations Kept In Mind During Eggs Donation
For a great deal of egg donation recipients, they have to comprehend the genetic foundation of their egg donor before settling on a definite conclusion on continuing with that particular egg donation program. This might require some exploration into the probability of their egg donation infant acquiring particular physical qualities.
Color of the Eyes does matter!
Coming towards the color of the eyes, this is one of the most essential traits to be anticipated to an extent, indeed, a scientific calculation. Predominant eye color qualities are as per the following: hazel, golden, blue, chestnut, green, dim and violet. The color of the eyes is likewise reviewed by three noteworthy hues, being chestnut, yellow and dim. The amount of every color in the eye will decide the eye color appearance all things considered. Green eyes have a considerable measure of yellow, while blue eyes have minimal yellow and no cocoa.
Genes an important feature
Genes are perplexing materials and setting out on an egg donation program implies you are receiving a set of genes. Whilst each one's viewpoint of a perfect egg donor program varies, an expert assessment in what to think about for as a flawless egg donor remains a sensibly decent physical and social match beyond what many would consider possible. If the egg donor is entirely like the beneficiary of donor eggs, then how nature makes up the supernatural occurrence infant is left to heavenly devices. An egg donation organization will have the capacity to manage beneficiaries about this in more detail.
Eggs Donation- Boon for Childless couple
There are various reasons why a couple would look for an egg donor, however a standout amongst the most well-known infirmities that can influence a women’s fertility, is known as POF or Premature Ovarian Failure, and it is an issue that can influence around 1 percent of the female populace over the world. It is a disorder that can be innate and additionally tending to influence women who are drawing nearer their thirties.
Infertility problems can happen to anybody and it is a more basic issue than the vast majority think, with more couples than any time in recent memory taking radical measures to defeat their challenges in conceiving. Infertility can influence either the man or the woman, and if the woman is infertile, then there is one alternative that is demonstrating famous, and that arrangement is to locate a suitable egg donor. Egg donation is seen by numerous couples, as their just trust in imagining a baby, despite the fact that the mother, who brings forth the youngster, won't be the organic mother of the child.
Whether you are seeking Frozen Egg Donation or normal egg, you can get it straight away from the egg donation bank. You can seek the internet to get a right kind of bank for frozen egg donation.
Color of the Eyes does matter!
Coming towards the color of the eyes, this is one of the most essential traits to be anticipated to an extent, indeed, a scientific calculation. Predominant eye color qualities are as per the following: hazel, golden, blue, chestnut, green, dim and violet. The color of the eyes is likewise reviewed by three noteworthy hues, being chestnut, yellow and dim. The amount of every color in the eye will decide the eye color appearance all things considered. Green eyes have a considerable measure of yellow, while blue eyes have minimal yellow and no cocoa.
Genes an important feature
Genes are perplexing materials and setting out on an egg donation program implies you are receiving a set of genes. Whilst each one's viewpoint of a perfect egg donor program varies, an expert assessment in what to think about for as a flawless egg donor remains a sensibly decent physical and social match beyond what many would consider possible. If the egg donor is entirely like the beneficiary of donor eggs, then how nature makes up the supernatural occurrence infant is left to heavenly devices. An egg donation organization will have the capacity to manage beneficiaries about this in more detail.
Eggs Donation- Boon for Childless couple
There are various reasons why a couple would look for an egg donor, however a standout amongst the most well-known infirmities that can influence a women’s fertility, is known as POF or Premature Ovarian Failure, and it is an issue that can influence around 1 percent of the female populace over the world. It is a disorder that can be innate and additionally tending to influence women who are drawing nearer their thirties.
Infertility problems can happen to anybody and it is a more basic issue than the vast majority think, with more couples than any time in recent memory taking radical measures to defeat their challenges in conceiving. Infertility can influence either the man or the woman, and if the woman is infertile, then there is one alternative that is demonstrating famous, and that arrangement is to locate a suitable egg donor. Egg donation is seen by numerous couples, as their just trust in imagining a baby, despite the fact that the mother, who brings forth the youngster, won't be the organic mother of the child.
Whether you are seeking Frozen Egg Donation or normal egg, you can get it straight away from the egg donation bank. You can seek the internet to get a right kind of bank for frozen egg donation.
Advertise on APSense
This advertising space is available.
Post Your Ad Here
Post Your Ad Here
Comments